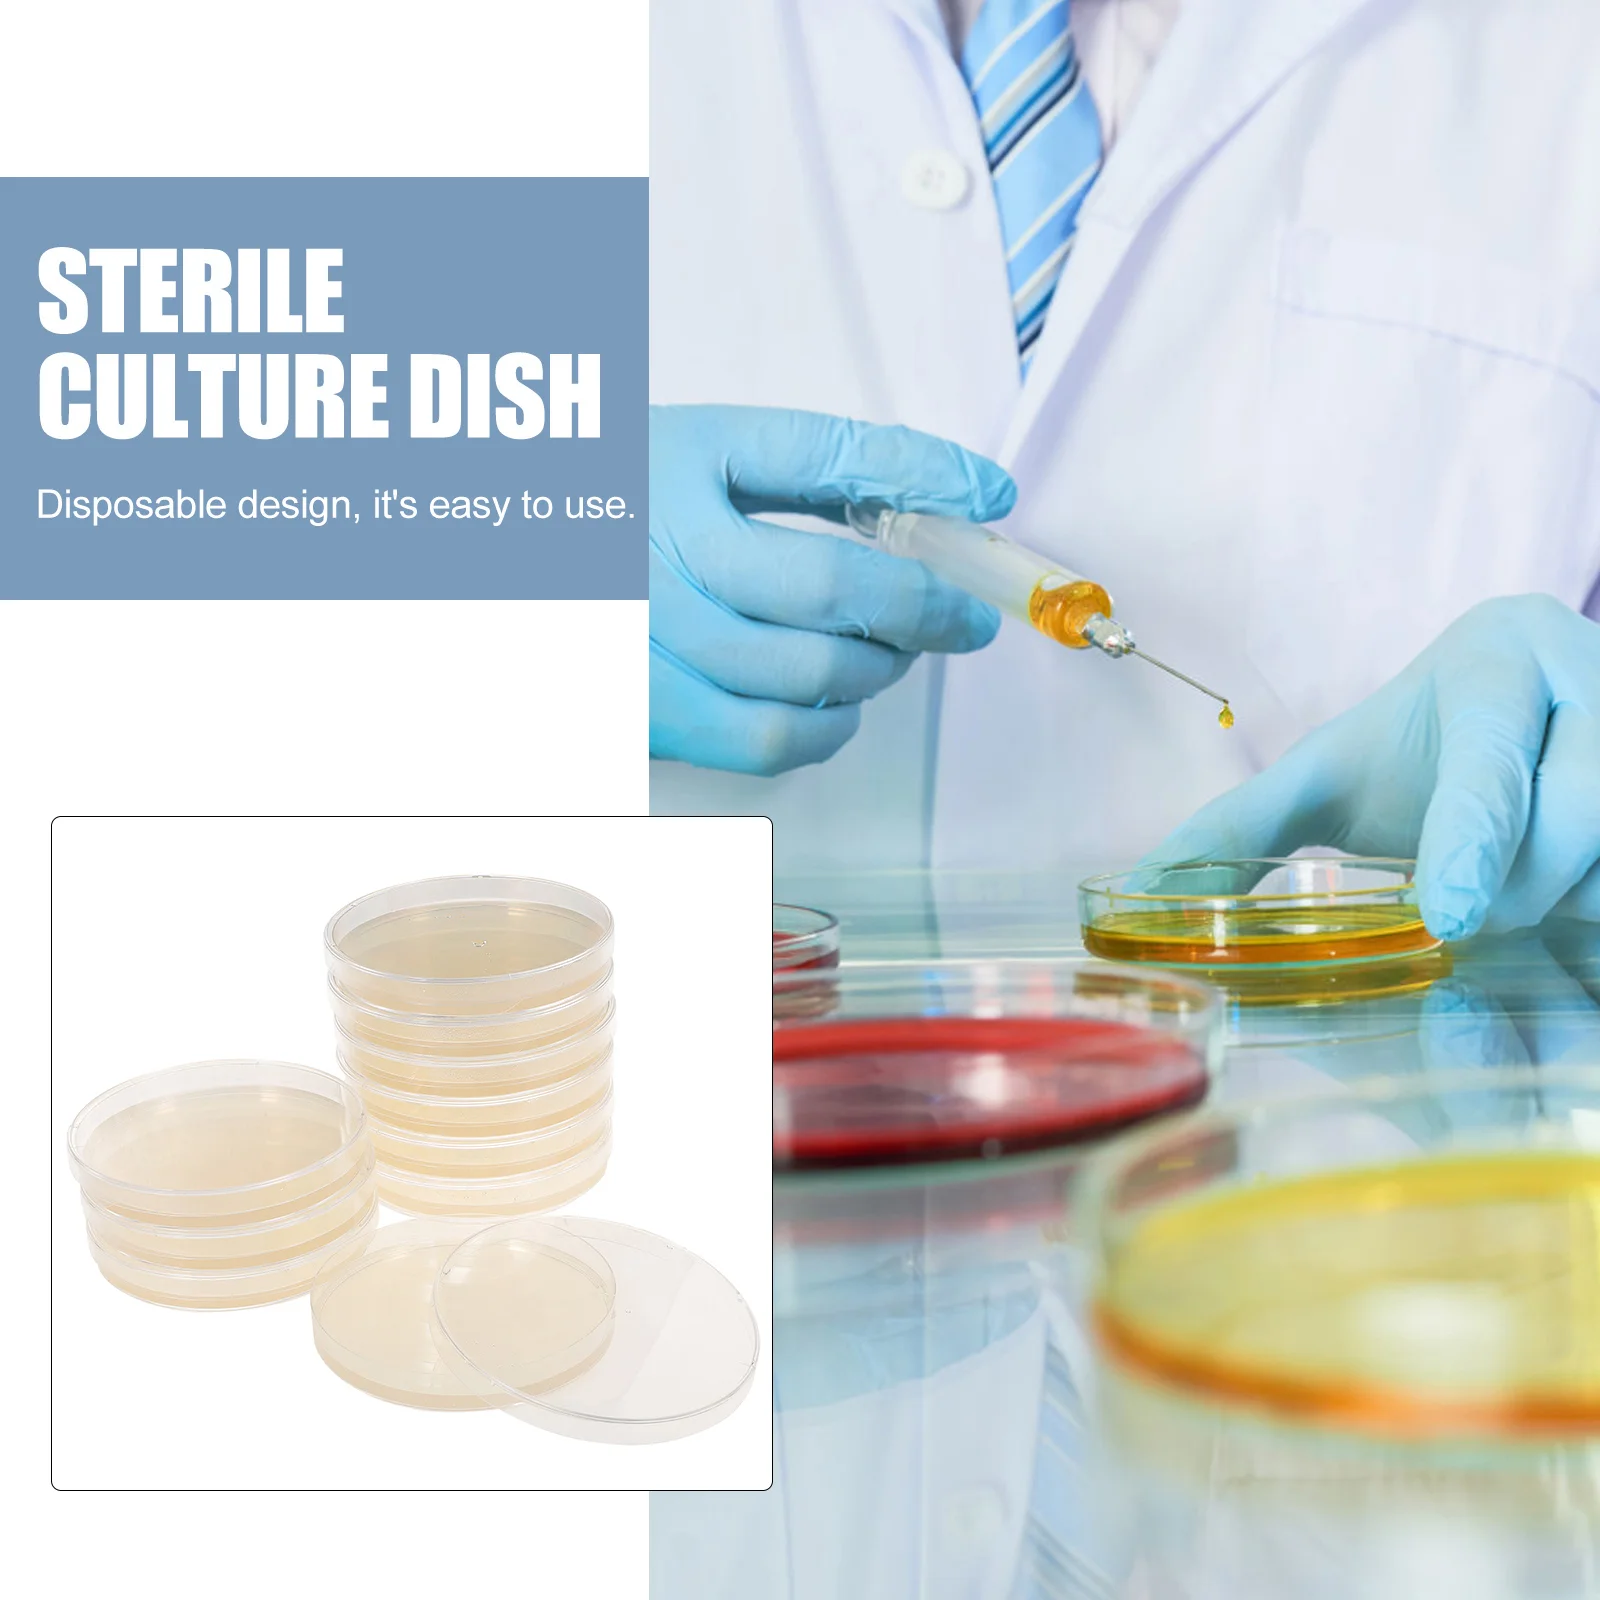
thumb

Стеклянные чаши Петри, питательные крышки, агаровая тарелка, грибы, лабораторные эксперименты, поставки желе
Price history chart & currency exchange rate
Customers also viewed

$13.46
Women Summer Mesh Lace Beach Shorts New Solid Colors Swimming Shorts High Waist Anti Transparency Trunks Sexy Beachwear Swimwear
aliexpress.com
$53.01
1PC Black 62800-B8000 Car Carrier Assy Spare Wheel Tire Bracket For-Hyundai Santa Fe 2013-2018
aliexpress.com
$52.08
Portable Electric Heating Tray Roll Up Food Warmer 3 Temperature Settings Timer Heating Pad Food Silicone Heating Pad
aliexpress.com
$57.72
Commercial Chocolate Melting Machine Capacity 4kg Electric Chocolate Heating Pots 800W 110V 220V
aliexpress.com
$58.86
Автомобильные напольные коврики для BYD Song Plus 2020, индивидуальные автомобильные накладки на ногу, аксессуары для интерьера
aliexpress.com
$172.80
Car rear trunk storage box Engine hood storage compartment for 23-24 A New Day NIO ES6
aliexpress.com
$204.90
Clear Clutch Cover For BMM F900R 2020 2021 / Motorcycle Engine Protector For BMW F 900 R
aliexpress.com
$407.74
Задний спойлер для Ford Mustang 2015 +, задний спойлер из углеродного волокна в роботизированном стиле, заднее крыло, задняя губа, задний хвост, обновленный корпус, комплект
aliexpress.com
$423.36
100M Lock Phase Constant Temperature Crystal Oscillator OCXO 10M Into 100M Out of Ultra Low Phase Noise
aliexpress.com
$998.94
Handheld Portable Ink Jet injec Machine Hand Held Inkjet Printer for Bottles Metal Plastic 2pcs Black Ink 2pcs Yellow Ink
aliexpress.com
$26.99
2 шт., накладки на задние и боковые окна BMW F30 3 серии 2013 2014 2015 2016 2017 2018 2019
aliexpress.com
$355.91
Simple Drying Clothes Rack Floor Heavy Balcony MultiAdjustable Nordic Hall Coat Rack Gold Modern Percha Pared Hall Furniture
aliexpress.com
$14.89
For HONDA NC750X 2014-2021 Motorcycle Radiator Guard Protector Grille Grill Cover NC750 750X 2020 2019 2018 NC 750 X 2015 2016
aliexpress.com
$29.69
5Pcs Bicycle Derailleur Hanger For BMC Teammachine Timemachine Disc Slr01 Slr02 URS Three #58 301092 #59 301093 MTB Mech Dropout
aliexpress.com
$4.34
Color Cosplayer Women Colorful Sexy Skeleton Printing Halloween Leggins Push Up Gym High Waist Push Up Strength Female Legging
aliexpress.com
$5.08
For Samsung Galaxy Z Flip 3 4 Cartoon Smiley Pattern Case For Samsung Galaxy ZFlip 4 3 Z Flip3 Zflip Cute Duck Shockproof Cover
aliexpress.com
$15.99
2022 Hot Fashion Men Hoodie Bad Bunny Long Sleeve Hip Hop Pullover Sweatshirt Top
aliexpress.com
$41.98
3Pc Center Console Dashboard Control Panel Gear Shift Cover Trim for-Jeep Wrangler JL JLU Gladiator Carbon Fiber Red
aliexpress.com
$98.41
5 PCS Camo Jacket Women Casual Print Long Sleeve Lady Short Coat Turn Down Collar Crop Tops Clothes Pockets Outer Wholesale 8795
aliexpress.com
$35.29
6-Piece Set Kitchen Tools Non-Stick Cookware For Kitchen Gadgets Accessories Cooking Utensils
aliexpress.com
$4.62
Sexy Dress Minnie Mouse Summer Dresses Woman 2022 Mickey V-Neck Fashion Disney Elegant Dresses for Women Long Sleeves Lace Party
aliexpress.com
$31.34
Мужской женский свитер VLONE, модный свободный свитер с рисунком в стиле ретро, 6879 хлопок,
aliexpress.ru